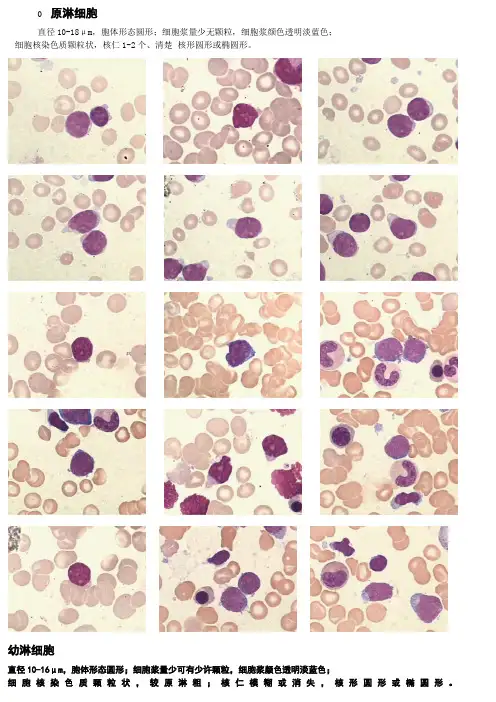

骨髓细胞图谱
- 格式:ppt
- 大小:5.86 MB
- 文档页数:176

0 原淋细胞
直径10-18μm ,胞体形态圆形;细胞浆量少无颗粒,细胞浆颜色透明淡蓝色; 细胞核染色质颗粒状,核仁1-2个、清楚 核形圆形或椭圆形。
幼淋细胞
直径10-16μm ,胞体形态圆形;细胞浆量少可有少许颗粒,细胞浆颜色透明淡蓝色;
细胞核染色质颗粒状,较原淋粗;核仁模糊或消失,核形圆形或椭圆形。
大淋巴细胞:
直径12-15μm 胞体形态圆形细胞浆量较多常有颗粒细胞浆颜色透明淡蓝色细胞核染色质粗块状核仁消失、有时有假核仁核形椭圆形、偏位
小淋巴细胞
直径6-9μm 胞体形态圆形细胞浆量极少常无颗粒细胞浆颜色透明淡蓝色
细胞核染色质粗块状核仁消失、有时有假核仁核形圆形、常有小切迹。

原始单核细胞(monoblast)
胞体:直径15-20μm,圆形或不规则,有时可有伪足。
胞核:圆形或不规则,染色质纤细(比原粒细)、呈疏松网状,核仁1-3个(多数为1个)、较大、清楚。
胞质:较其他原始细胞多,呈灰蓝色或淡蓝色、不透明、毛玻璃样。
幼稚单核细胞 (premonocyte)
胞体:直径15-25μm,圆形或不规则,有时可有伪足。
胞核:圆形或不规则,呈扭曲折叠状,有凹陷或切迹,染色质开始聚集、呈丝网状,核仁模糊或消失。
胞质:较多,呈灰蓝色,可见细小紫红色的嗜天青颗粒。
单核细胞(monocyte)
胞体:直径12-20μm,不规则,有有时可见伪足。
胞核:不规则,常呈肾形、大肠状、马蹄状、马蹄形、"S形"、分叶形、笔架形等,染色质疏松,可呈条索状。
胞质:灰蓝色或灰红色、半透明如毛玻璃样,浆内见细小、分布均匀的灰尘样紫红色颗粒,有时偶见空泡。